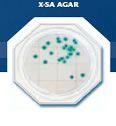
Food Stamp X-SA Agar - Staphylococcus aureus

Food Stamp X-SA Agar - Staphylococcus aureus
Pret: neprecizat
Producator: Japonia
Produs publicat de: ATC INVESTMENT -- Iasi (Iasi) , telefon: 0744620271 / 0744620271
Producator: Japonia
Produs publicat de: ATC INVESTMENT -- Iasi (Iasi) , telefon: 0744620271 / 0744620271
Solicitare informații / comandă produs (mesaj către ATC INVESTMENT):
Nr. vizite 2005